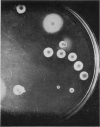
412-1

Full text
PDF
















Images in this article
Selected References
These references are in PubMed. This may not be the complete list of references from this article.
- Bunting M. I. The Production of Stable Populations of Color Variants of Serratia marcescens, # 274 in Rapidly Growing Cultures. J Bacteriol. 1940 Jul;40(1):69–81. doi: 10.1128/jb.40.1.69-81.1940. [DOI] [PMC free article] [PubMed] [Google Scholar]
- Edwards P. R., Bruner D. W. Notes on Monophasic Salmonella Cultures and Their Use in the Production of Diagnostic Serums. J Bacteriol. 1946 Oct;52(4):493–498. doi: 10.1128/jb.52.4.493-498.1946. [DOI] [PMC free article] [PubMed] [Google Scholar]
- Luria S. E., Delbrück M. Mutations of Bacteria from Virus Sensitivity to Virus Resistance. Genetics. 1943 Nov;28(6):491–511. doi: 10.1093/genetics/28.6.491. [DOI] [PMC free article] [PubMed] [Google Scholar]